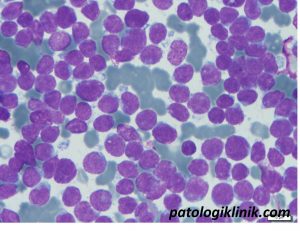
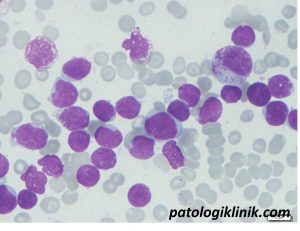
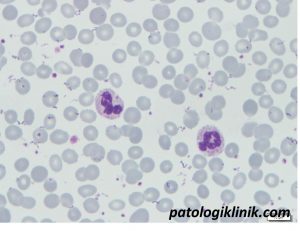
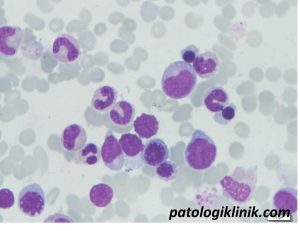

Cara Menentukan Kriteria Remisi AML

Pagi ini seorang anak laki-laki, sebut saja Adi, usia 13 tahun datang untuk dilakukan pemeriksaan sumsum tulang (BMP). Pemeriksaan ini dilakukan sebagai tindak lanjut dari kemoterapi yang telah dilakukan. Adi telah didiagnosis leukemia mieloblastik akut tanpa maturasi (AML-M1) sejak lima bulan yang lalu dan telah dilakukan dua kali BMP.
Saat pertama kali didiagnosis, Adi mengeluhkan lemah badan dan pucat. Adi juga sering mengeluh panas tinggi, yang turun saat diberikan obat penurun panas. Pemeriksaan laboratorium saat itu menunjukkan kadar Hb 5 g/dl, netrofil 640 mcl dan trombosit 50.000 /mcl. Pada pemeriksaan evaluasi apusan darah tepi dan BMP, lapang pandang didominasi oleh mieloblas, dengan proliferasi sel mieloblas pada sumsum tulang sekitar 80%. Diagnosis AML-M1 ditegakkan berdasarkan data-data tersebut.

Pada BMP yang ketiga ini, sudah tidak ada lemah badan dan pucat, hanya saat opname Adi mengeluh panas badan. Kadar Hb sudah meningkat menjadi 11,3 g/dl, netrofil 6.000 /mcl dan trombosit 722.000/ml. Pada pemeriksaan evaluasi apusan darah tepi dan BMP sudah tidak ditemukan lagi sel mieloblas. Berdasarkan data tersebut, bagaimanakah kesimpulan hasil BMP Adi?

Dengan melihat kedua gambar hasil pemeriksaan di atas, dapat dilihat dengan jelas terdapat perbedaan yang bermakna dari parameter darah lengkap dan jumlah mieloblas. Bagaimana pedoman lengkap cara menentukan kriteria remisi dari AML?
Sebenarnya ada beberapa kriteria remisi komplit AML, yaitu remisi komplit morfologik, remisi komplit sitogenetik, dan remisi komplit molekuler. Selain remisi komplit, juga dikenal remisi parsial dan gagal terapi (failure). Di rumah sakit tempat saya bekerja, juga hampir seluruh rumah sakit di Indonesia, keterbatasan fasilitas pemeriksaan imunofenotipe dan sitogenetik masih menjadi kendala utama dalam diagnosis dan tindak lanjut terapi leukemia, sehingga identifikasi morfologi masih menjadi alat utama. Begitupun dengan penentuan kriteria remisi, masih berdasarkan pada hasil darah lengkap dan morfologi.
AML dikatakan mencapai remisi komplit morfologik jika jumlah netrofil absolut >1.000/mcl,trombosit >100.000/mcl, sel blas <5%, dan tidak ada auer rod. Jika sel blas sumsum tulang <5%, tetapi jumlah netrofil absolut <1.000/mcl dan/atau trombosit <100.000/mcl maka disebut remisi komplit morfologik dengan incomplete blood count recovery. Jika pada sumsum tulang masih ditemukan sel blas 5-25% (dengan penurunan jumlah sel blas >50% dari pemeriksaan awal atau sel blas <5% dengan auer rod (+), maka disebut remisi parsial. Jika pada sumsum tulang dan darah tepi masih ditemukan sel blas dengan jumlah yang relatif sama dengan saat BMP awal, maka disebut stadium failure (gagal terapi). Terdapat tiga macam stadium failure, yaitu resistant, aplasia, dan indeterminate. Setelah mencapai stadium remisi komplit, sel blas masih bisa muncul kembali di darah tepi dan sumsum tulang. Stadium ini disebut dengan stadium relaps.
Dari hasil data pemeriksaan Adi terakhir didapatkan netrofil absolut >1.000/mcl, trombosit >100.000/mcl, dan sel mieloblas sudah tidak ditemukan lagi pada darah tepid an sumsum tulang, sehingga bisa disimpulkan Adi sudah mencapai stadium remisi komplit morfologik.
Semoga bermanfaat.
Sumber:
Cheson BD, Bennett JM, Kopecky KJ, et al. 2004. Revised Recommendations of the International Working Group for Diagnosis, Standardization of Response Criteria, Treatment Outcomes, and Reporting Standards for Therapeutic Trials in Acute Myeloid Leukemia. Journal of Clinical Oncology, Vol 21(24): 4642-4649




![[Download] Pedoman Nasional Pelayanan Kedokteran Tata Laksana Thalassemia (KMK)](/content/images/uploads/2022/10/KMK.jpg)
![[Download] Pemeriksaan Laboratorium pada Thalassemia](/content/images/uploads/2022/09/cover-web-scaled.jpg)